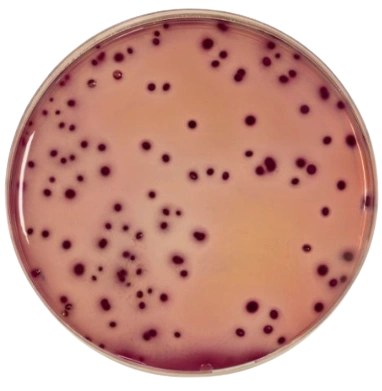
image

Flüssigmedien
Thioglycollate Vit K Hemin Broth, RPD
- Art.Nr. 12048252
- Ref.Nr. ALTA0125
Ab Lager lieferbar (Lieferzeit: 1-3 Werktage)
28.75
Dokumente
–
+
Thomann Transport & Enrichment Medium (TTE), 10 x 60 ml, RPD
- Art.Nr. 12064689
- Ref.Nr. ALBA8993
Lieferzeit gemäss Auftragsbestätigung
43.15
Dokumente
–
+
Violet Red Bile Glucose Agar ( VRBG), 10 x 200ml, Biokar
Violett-Rot-Galle-Glukose-Agar mit Kristallviolett und Neutralrot (VRBG-Agar) wurde von Mossel zur Nachweis- und Zählbestimmung von Enterobakterien in Milchprodukten, Fleisch, zubereiteten Schweinefleischerzeugnissen und anderen Lebensmitteln verwendet. Das Nährmedium kann auch zum Nachweis von gramnegativen, gallensalzbeständigen Bakterien bei der mikrobiologischen Kontrolle nicht steriler Produkte eingesetzt werden.
- Art.Nr. 10038445
- Ref.Nr. BM07508
Ab Lager lieferbar (Lieferzeit: 1-3 Werktage)
33.75
Dokumente
–
+
LISTERIA FRASER BROTH HALF CONCENTRATION, 6x225ml, Biolife
- Art.Nr. 12073568
- Ref.Nr. 5115943
Ab Lager lieferbar (Lieferzeit: 1-3 Werktage)
35.70
Dokumente
–
+
.webp?width=400&ts=1752795772)
Buffered Peptone Water, 50 x 9ml, Biokar
- Art.Nr. 10038435
- Ref.Nr. BM05608
Ab Lager lieferbar (Lieferzeit: 1-3 Werktage)
45.80
Dokumente
–
+
Staphylokokken Anreicherungsbouillon, 100 x 3.0 ml, Axonbiotech GmbH
Die Anreicherungsbouillon dient zum Anreichern von MRSA und MSSA.
- Art.Nr. 10034853
- Ref.Nr. AL0601
Ab Lager lieferbar (Lieferzeit: 1-3 Werktage)
141.70
Dokumente
–
+
LISTERIA FRASER BROTH - 20 x 10 ml, 20 x 10ml, Biolife
- Art.Nr. 11000904
- Ref.Nr. 551596
Ab Lager lieferbar (Lieferzeit: 1-3 Werktage)
29.80
Dokumente
–
+
TSB + Tween + Lecithine, RPD
- Art.Nr. 12048190
- Ref.Nr. ALBA8231
Lieferzeit gemäss Auftragsbestätigung
39.05
Dokumente
–
+
E.E Mossel Broth, 20 x 9ml, RPD
- Art.Nr. 12054884
- Ref.Nr. ALTA0189
Ab Lager lieferbar (Lieferzeit: 1-3 Werktage)
34.35
Dokumente
–
+

Symphony Agar, 10 x 200 mL, Biokar
Symphony Agar
- Art.Nr. 11000373
- Ref.Nr. BM19108
Ab Lager lieferbar (Lieferzeit: 1-3 Werktage)
102.50
Dokumente
–
+
Penicillin G 500 IU Selective Supplement, 10 tubes, Biolife
- Art.Nr. 12072519
- Ref.Nr. 4240050
Ab Lager lieferbar (Lieferzeit: 1-3 Werktage)
59.15
Dokumente
–
+

Confirm L.mono broth, 18 x 1ml, Biokar
- Art.Nr. 10038497
- Ref.Nr. BM16208
Ab Lager lieferbar (Lieferzeit: 1-3 Werktage)
84.45
Dokumente
–
+
Mehr laden
12